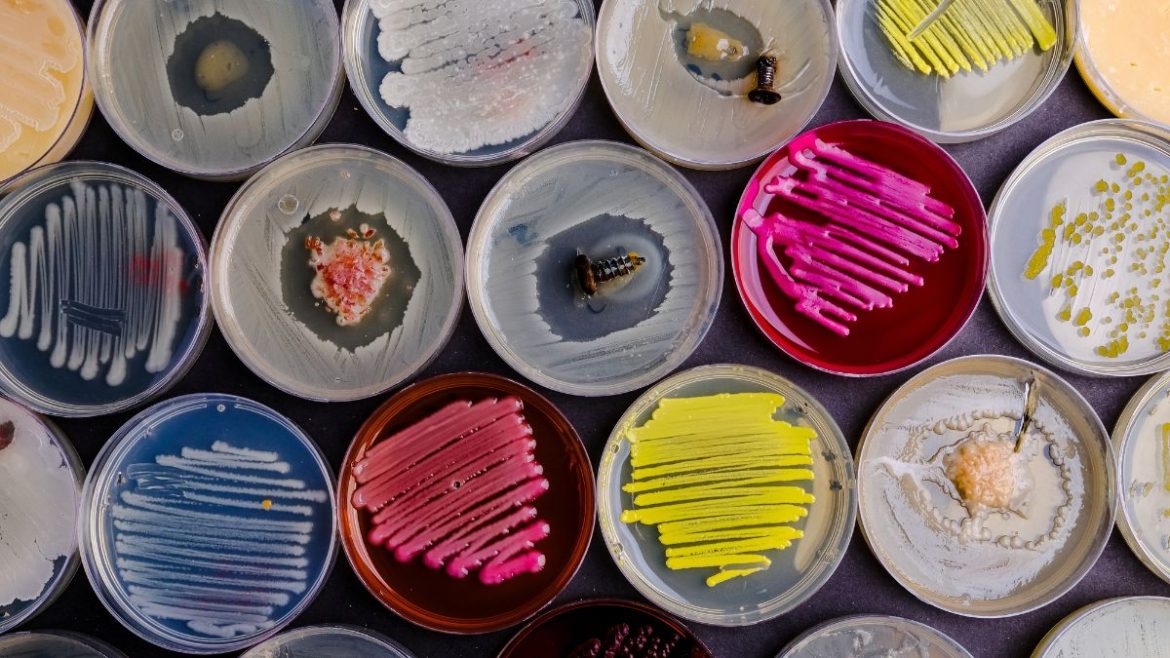
Pharma Article Covers – 2025-10-29T163252.334 Αντιβιοτικά Βακτηριακή αντίσταση

Χημικοί από το Πανεπιστήμιο του Warwick και το Πανεπιστήμιο Monash έχουν εντοπίσει ένα πολλά υποσχόμενο νέο αντιβιοτικό που μπορεί να καταπολεμήσει τις ανθεκτικές στα φάρμακα βακτηριακές λοιμώξεις, συμπεριλαμβανομένων των MRSA (Methicillin Resistant Staphylococcus Aureus) και VRE (Vancomycin Resistant Enterococcus).
Η αντιμικροβιακή αντοχή (AMR) θεωρείται μία από τις σοβαρότερες απειλές για την παγκόσμια υγεία
Ο Παγκόσμιος Οργανισμός Υγείας (ΠΟΥ) προειδοποίησε πρόσφατα ότι «υπάρχουν πολύ λίγα αντιβακτηριακά φάρμακα σε φάση ανάπτυξης» και ότι τα πιο εύκολα ανιχνεύσιμα αντιβιοτικά έχουν ήδη ανακαλυφθεί. Επειδή η ανάπτυξη νέων αντιβιοτικών είναι δαπανηρή και προσφέρει περιορισμένη οικονομική ανταμοιβή, λίγες φαρμακευτικές εταιρείες επενδύουν σε αυτόν τον κρίσιμο τομέα.
Ανακάλυψη ενός κρυμμένου ενδιάμεσου αντιβιοτικού
Σε πρόσφατο άρθρο στο Journal of the American Chemical Society, ερευνητές από την Monash Warwick Alliance Combatting Emerging Superbug Threats Initiative ανέφεραν την ανακάλυψη ενός ισχυρού νέου αντιβιοτικού που ονομάζεται προ-μεθυλενομυκίνη C λακτόνη. Η ένωση «κρυβόταν σε κοινή θέα» ως ενδιάμεση χημική ουσία στη φυσική διαδικασία που παράγει το γνωστό αντιβιοτικό μεθυλενομυκίνη Α.
Ο καθηγητής Greg Challis, συν-συγγραφέας από το Τμήμα Χημείας του Πανεπιστημίου του Warwick και το Ινστιτούτο Ανακαλύψεων Βιοϊατρικής του Πανεπιστημίου Monash, εξήγησε: «Η μεθυλενομυκίνη Α ανακαλύφθηκε αρχικά πριν από 50 χρόνια και, παρόλο που έχει συντεθεί αρκετές φορές, κανείς δεν φαίνεται να έχει δοκιμάσει τα συνθετικά ενδιάμεσα προϊόντα για αντιμικροβιακή δράση! Με τη διαγραφή των βιοσυνθετικών γονιδίων, ανακαλύψαμε δύο προηγουμένως άγνωστα βιοσυνθετικά ενδιάμεσα προϊόντα, τα οποία είναι πολύ πιο ισχυρά αντιβιοτικά από την ίδια τη μεθυλενομυκίνη Α».
100πλάσια αύξηση της αντιβακτηριακής ισχύος.

Εργαστηριακή ανακάλυψη
Κατά τη δοκιμή, ένα από αυτά τα ενδιάμεσα προϊόντα — η προ-μεθυλενομυκίνη C λακτόνη — αποδείχθηκε ότι είναι πάνω από 100 φορές πιο δραστικό έναντι μιας σειράς Gram-θετικών βακτηρίων από τη μεθυλενομυκίνη Α. Ήταν ιδιαίτερα αποτελεσματικό κατά του Staphylococcus aureus και του Enterococcus faecium, των βακτηριακών ειδών που ευθύνονται για το Methicillin-resistant Staphylococcus aureus (MRSA) και το Vancomycin-resistant Enterococcus (VRE).
Η συν-συγγραφέας της μελέτης, Δρ. Lona Alkhalaf, επίκουρη καθηγήτρια στο Πανεπιστήμιο του Warwick, δήλωσε: «Είναι αξιοσημείωτο ότι το βακτήριο που παράγει μεθυλενομυκίνη Α και προ-μεθυλενομυκίνη C λακτόνη — το Streptomyces coelicolor — είναι ένα πρότυπο είδος που παράγει αντιβιοτικά και έχει μελετηθεί εκτενώς από τη δεκαετία του 1950. Η ανακάλυψη ενός νέου αντιβιοτικού σε έναν τόσο γνωστό οργανισμό ήταν μια πραγματική έκπληξη».
Πρόσθεσε ότι φαίνεται ότι το S. coelicolor μπορεί να εξελίχθηκε αρχικά για να παράγει ένα ισχυρό αντιβιοτικό (προ-μεθυλενομυκίνη C λακτόνη), αλλά με την πάροδο του χρόνου μετατράπηκε στην παραγωγή μεθυλενομυκίνης Α, μιας ασθενέστερης μορφής που θα μπορούσε να εξυπηρετήσει έναν διαφορετικό βιολογικό ρόλο.
Είναι ενθαρρυντικό το γεγονός ότι η ερευνητική ομάδα δεν βρήκε ενδείξεις βακτηριακής αντοχής στην προ-μεθυλενομυκίνη C λακτόνη στον Enterococcus υπό συνθήκες που συνήθως οδηγούν σε αντοχή στη βανκομυκίνη. Δεδομένου ότι η βανκομυκίνη είναι συχνά η «τελευταία λύση» για τη θεραπεία αυτών των λοιμώξεων, αυτό το αποτέλεσμα είναι ένα ιδιαίτερα ελπιδοφόρο σημάδι για την αντιμετώπιση του VRE, το οποίο ο ΠΟΥ κατατάσσει ως παθογόνο υψηλής προτεραιότητας.
Μια νέα κατεύθυνση για την ανακάλυψη αντιβιοτικών
Ο καθηγητής Challis σημείωσε: «Αυτή η ανακάλυψη υποδηλώνει ένα νέο πρότυπο για την ανακάλυψη αντιβιοτικών. Με την αναγνώριση και τη δοκιμή ενδιάμεσων προϊόντων στις οδούς προς διάφορες φυσικές ενώσεις, ενδέχεται να βρούμε νέα ισχυρά αντιβιοτικά με μεγαλύτερη ανθεκτικότητα στην αντοχή, τα οποία θα μας βοηθήσουν στην καταπολέμηση της AMR».
Το επόμενο βήμα στην ανάπτυξη του αντιβιοτικού θα είναι οι προκλινικές δοκιμές. Σε μια συντονισμένη δημοσίευση νωρίτερα φέτος στο Journal of Organic Chemistry, μια ομάδα με επικεφαλής τον Monash, σε συνεργασία με την ομάδα του Warwick και με χρηματοδότηση από την πρωτοβουλία Monash Warwick Alliance Combatting Emerging Superbug Threats, ανέφερε μια κλιμακωτή σύνθεση της προ-μεθυλενομυκίνης C λακτόνης, ανοίγοντας το δρόμο για περαιτέρω έρευνα.
Ο καθηγητής David Lupton, της Σχολής Χημείας του Πανεπιστημίου Monash, ο οποίος ηγήθηκε του έργου σύνθεσης, δηλώνει: «Αυτή η συνθετική οδός θα πρέπει να επιτρέψει τη δημιουργία ποικίλων αναλόγων που μπορούν να χρησιμοποιηθούν για τη διερεύνηση της σχέσης δομής-δραστηριότητας και του μηχανισμού δράσης της προ-μεθυλενομυκίνης C λακτόνης.
Το Κέντρο για την Αντιμετώπιση της Αντοχής στα Αντιμικροβιακά Φάρμακα του Πανεπιστημίου Monash μας παρέχει μια εξαιρετική πλατφόρμα για την προώθηση αυτού του πολλά υποσχόμενου αντιμικροβιακού φαρμάκου.
Με την απλή χημική του δομή, την ισχυρή αντιβακτηριακή του δράση, το προφανές προφίλ αντοχής στην αντοχή και την επεκτάσιμη διαδικασία παραγωγής του, το προ-μεθυλενομυκίνη C λακτόνη ξεχωρίζει ως ένας πολλά υποσχόμενος νέος υποψήφιος. Τελικά, θα μπορούσε να συμβάλει στη διάσωση πολλών από τις 1,1 εκατομμύρια ζωές που χάνονται κάθε χρόνο εξαιτίας της μικροβιακής αντοχής.
Πηγή: sciencedaily.com